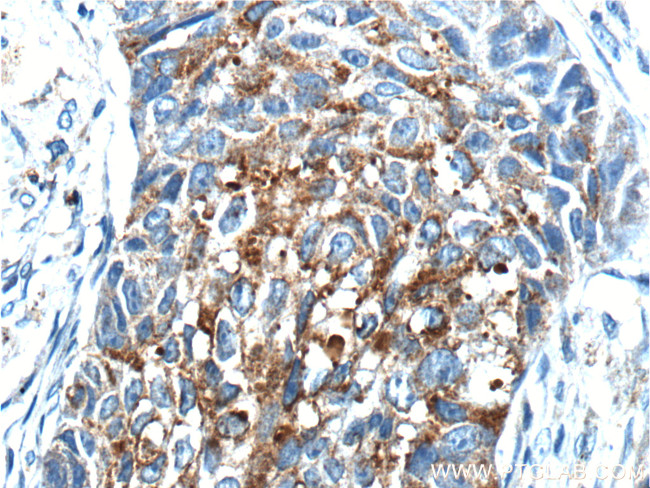
RPN2 Antibody in Immunohistochemistry (Paraffin) (IHC (P))

Search
Proteintech
RPN2 Polyclonal Antibody
{{$productOrderCtrl.translations['antibody.pdp.commerceCard.promotion.promotions']}}
{{$productOrderCtrl.translations['antibody.pdp.commerceCard.promotion.viewpromo']}}
{{$productOrderCtrl.translations['antibody.pdp.commerceCard.promotion.promocode']}}: {{promo.promoCode}} {{promo.promoTitle}} {{promo.promoDescription}}. {{$productOrderCtrl.translations['antibody.pdp.commerceCard.promotion.learnmore']}}
产品信息
10576-1-AP
种属反应
已发表种属
宿主/亚型
分类
类型
抗原
偶联物
形式
浓度
规格
纯化类型
保存液
内含物
保存条件
运输条件
产品详细信息
Immunogen sequence: VGTEPSIKE DQVIQLMNAI FSKKNFESLS EAFSVASAAA VLSHNRYHVP VVVVPEGSAS DTHEQAILRL QVTNVLSQPL TQATVKLEHA KSVASRATVL QKTSFTPVGD VFELNFMNVK FSSGYYDFLV EVEGDNRYIA NTVELRVKIS TEVGITNVDL STVDKDQSIA PKTTRVTYPA KAKGTFIADS HQNFALFFQL VDVNTGAELT PHQTFVRLHN QKTGQEVVFV AE (222-452 aa encoded by BC003560)
靶标信息
RNP2 a type I integral membrane protein found only in the rough endoplasmic reticulum. The encoded protein is part of an N-oligosaccharyl transferase complex that links high mannose oligosaccharides to asparagine residues found in the Asn-X-Ser/Thr consensus motif of nascent polypeptide chains. This protein is similar in sequence to the yeast oligosaccharyl transferase subunit SWP1.
仅用于科研。不用于诊断过程。未经明确授权不得转售。
生物信息学
蛋白别名: Dolichyl-diphosphooligosaccharide--protein glycosyltransferase 63 kDa subunit; Dolichyl-diphosphooligosaccharide--protein glycosyltransferase subunit 2; oligosaccharyltransferase complex subunit (non-catalytic); RIBIIR; ribophorin 2; Ribophorin II; Ribophorin-2; RPN-II; RPN2; unnamed protein product
基因别名: 1300012C06Rik; AV261018; RIBIIR; Rpn-2; RPN-II; RPN2; RPNII; SWP1
UniProt ID: (Human) P04844, (Rat) P25235, (Mouse) Q9DBG6
Entrez Gene ID: (Human) 6185, (Rat) 64701, (Mouse) 20014